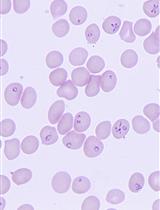
促进巴贝虫生物学、发病机制和治疗的巴贝虫培养和小鼠（ICIM）模型

(*contributed equally to this work) 发布: 2018年12月20日第8卷第24期 DOI: 10.21769/BioProtoc.3122 浏览次数: 6603
评审: Ruth A. FranklinMigla MiskinyteBenoit Stijlemans

相关实验方案

基于TruCount™微珠的肠上皮内淋巴细胞绝对计数标准化流式细胞术方法
Corentin Joulain [...] Salima Hacein-Bey-Abina
2025年05月05日 2171 阅读
Abstract
Eimeria vermiformis is a tissue specific, intracellular protozoan that infects the murine small intestinal epithelia, which has been widely used as a coccidian model to study mucosal immunology. This mouse infection model is valuable to investigate the mechanisms of host protection against primary and secondary infection in the small intestine. Here, we describe the generation of an E. vermiformis stock solution, preparation of sporulated E. vermiformis to infect mice and determination of oocysts burden. This protocol should help to establish a highly reproducible natural infection challenge model to study immunity in the small intestine. The information obtained from using this mouse model can reveal fundamental mechanisms of interaction between the pathogen and the immune response, e.g., provided by intraepithelial lymphocytes (IEL) at the basolateral site of epithelial cells but also a variety of other immune cell populations present in the gut.
Keywords: Eimeria vermiformis (蠕形艾美耳球虫)Background
Infections of the small intestine are widespread and can cause significant morbidity and mortality worldwide (Munot and Kotler, 2016). Children and the elderly, due to their weaker immune system, suffer the worst consequences. Gaining a better understanding of how the small intestinal immune system functions is therefore of prime importance. However, many of the pathogens used in mouse models are not natural to the host, can cause systemic inflammation or can persist in the tissues for long periods. This can result in uncharacteristic induction of the immune response and inadequate development of protective immunity.
Eimeria vermiformis is a tissue specific, intracellular single cell protozoan, which infects the small intestinal epithelia. Unlike the related pathogen used in infection models, Toxoplasma gondii, this is a natural, self-limiting, murine parasite, which induces a strong immune response and establishes long-lasting protection against subsequent infections. Furthermore, E. vermiformis is monoxenous, its life cycle is completed without the need of a second host species (see Figure 1). It is therefore an ideal pathogen to study the mechanisms of host protection against primary and secondary infection at the small intestinal barrier.
Mice infected with E. vermiformis excrete a non-infectious, unsporulated form of oocysts into the environment. Once in contact with oxygen and moisture, in a process which takes between 2 to 7 days, these oocysts mature into an infectious, sporulated form, which, upon ingestion, disseminates the infection to other animals (Fayer, 1980).
The E. vermiformis infection model has been used in the past and has yielded valuable information in areas such as the role of αβ and γδ T cells that line the small intestinal epithelia (Roberts et al., 1996) and the influence of age of the host in the development of protective immune responses in the intestine (Ramsburg et al., 2003). More recently we have used the E. vermiformis model to highlight the role of mitochondria in controlling the activation state of epithelial-resident T lymphocytes (Konjar et al., 2018).
Here, we present an adapted version of the original protocol used by Long et al. (1976) to purify and sporulate E. vermiformis. We describe in detail the method used to propagate the parasite, infect mice and accurately assess parasite load.
Figure 1. E. vermiformis life cycle. A single sporulated oocyst can initiate an infection when swallowed by its respective host, the mouse. Each mature oocyst holds four sporocysts, each sporocyst gives rise to two sporozoites, which can infect the enterocytes. Inside the host cell, the parasite develops via trophozoite and schizont stages into merozoites. Merozoites can re-infect the epithelial cells and start a new cycle. Eimeria typically undergoes three rounds of asexual multiplication whereupon merozoites give rise to gametes. Male and female gametes can fuse to form an oocyst, protected by a multi-layered cell wall making them highly resistant to environmental pressures. These oocysts shed with the feces. Unsporulated oocysts undergo sporulation upon contact with oxygen and moisture, undergoing meiosis, which takes between 2 to 7 days.
Materials and Reagents
Equipment
Procedure
文章信息
版权信息
© 2018 The Authors; exclusive licensee Bio-protocol LLC.
如何引用
Figueiredo-Campos, P., Ferreira, C., Blankenhaus, B. and Veldhoen, M. (2018). Eimeria vermiformis Infection Model of Murine Small Intestine. Bio-protocol 8(24): e3122. DOI: 10.21769/BioProtoc.3122.
分类
免疫学 > 粘膜免疫学 > 上皮
微生物学 > 体内实验模型 > 原生动物
细胞生物学 > 模式生物培养 > 保存
您对这篇实验方法有问题吗?
在此处发布您的问题,我们将邀请本文作者来回答。同时,我们会将您的问题发布到Bio-protocol Exchange,以便寻求社区成员的帮助。
Share
Bluesky
X
Copy link